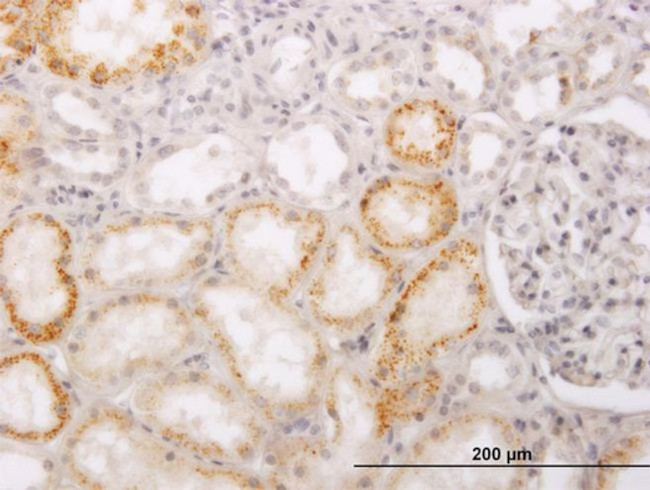
ACCS Antibody in Immunohistochemistry (Paraffin) (IHC (P))

Search
Invitrogen
ACCS Monoclonal Antibody (1D2)
{{$productOrderCtrl.translations['antibody.pdp.commerceCard.promotion.promotions']}}
{{$productOrderCtrl.translations['antibody.pdp.commerceCard.promotion.viewpromo']}}
{{$productOrderCtrl.translations['antibody.pdp.commerceCard.promotion.promocode']}}: {{promo.promoCode}} {{promo.promoTitle}} {{promo.promoDescription}}. {{$productOrderCtrl.translations['antibody.pdp.commerceCard.promotion.learnmore']}}
产品信息
MA5-24497
种属反应
宿主/亚型
分类
类型
克隆号
抗原
偶联物
形式
规格
纯化类型
保存液
内含物
保存条件
运输条件
RRID
产品详细信息
Peptide Sequence: MFTLPQKDFR APTTCLGPTC MQDLGSSHGE DLEGECSRKL DQKLPELRGV GDPAMISSDT SYLSSRGRMI KWFWDSAEEG YRTYHMDEYD EDKNPSGIIN
靶标信息
Does not catalyze the synthesis of 1-aminocyclopropane- 1-carboxylate but is capable of catalyzing the deamination of L- vinylglycine.
仅用于科研。不用于诊断过程。未经明确授权不得转售。
篇参考文献 (0)
生物信息学
蛋白别名: 1-aminocyclopropane-1-carboxylate synthase homolog (Arabidopsis)(non-functional) isoform ACCS_1; 1-aminocyclopropane-1-carboxylate synthase homolog (Arabidopsis)(non-functional) isoform ACCS_2; 1-aminocyclopropane-1-carboxylate synthase homolog (Arabidopsis)(non-functional) isoform ACCS_4; 1-aminocyclopropane-1-carboxylate synthase-like protein 1; ACC synthase-like protein 1; pyridoxal phosphate-dependent enzyme; unnamed protein product
基因别名: ACCS; ACS; PHACS
UniProt ID: (Human) Q96QU6
Entrez Gene ID: (Human) 84680